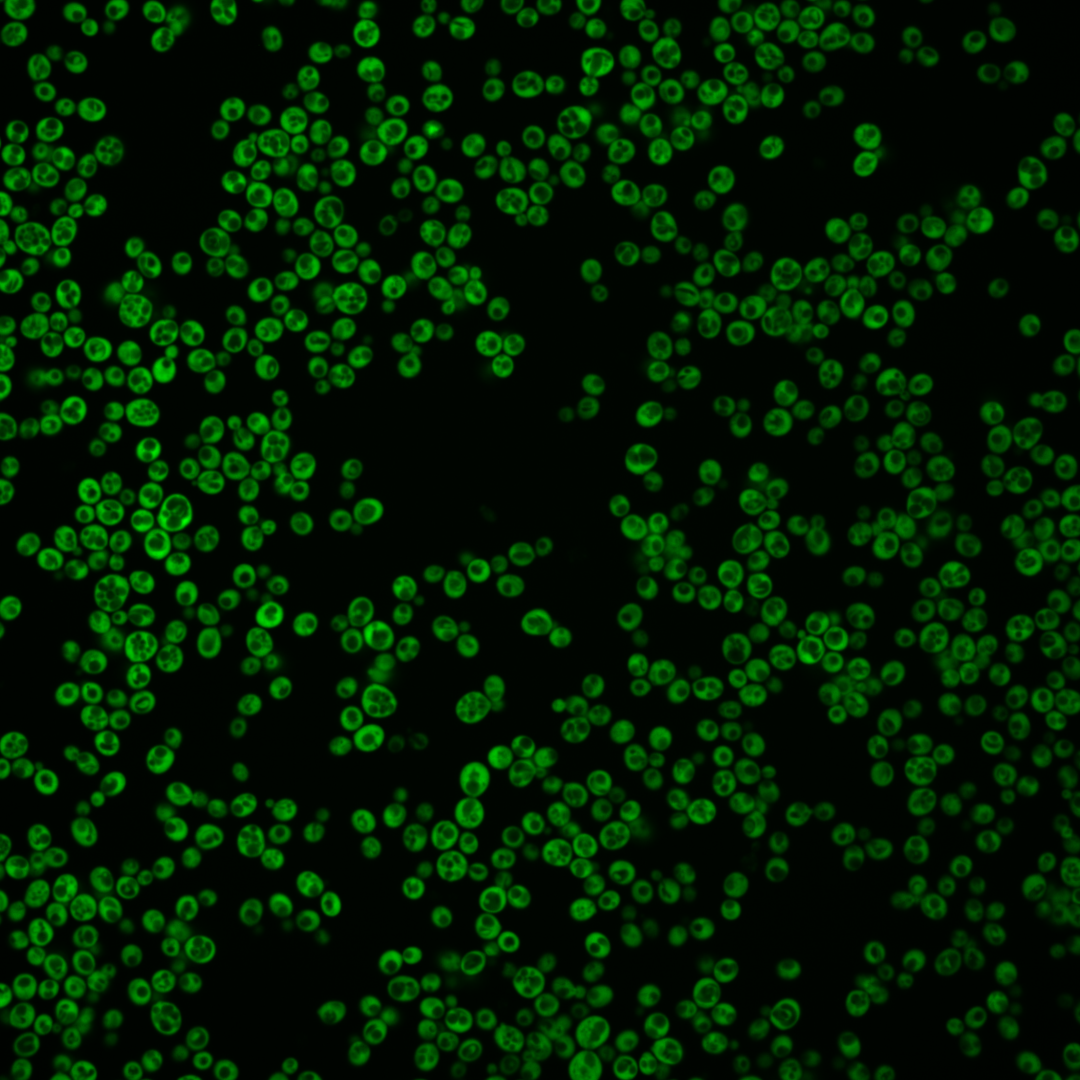
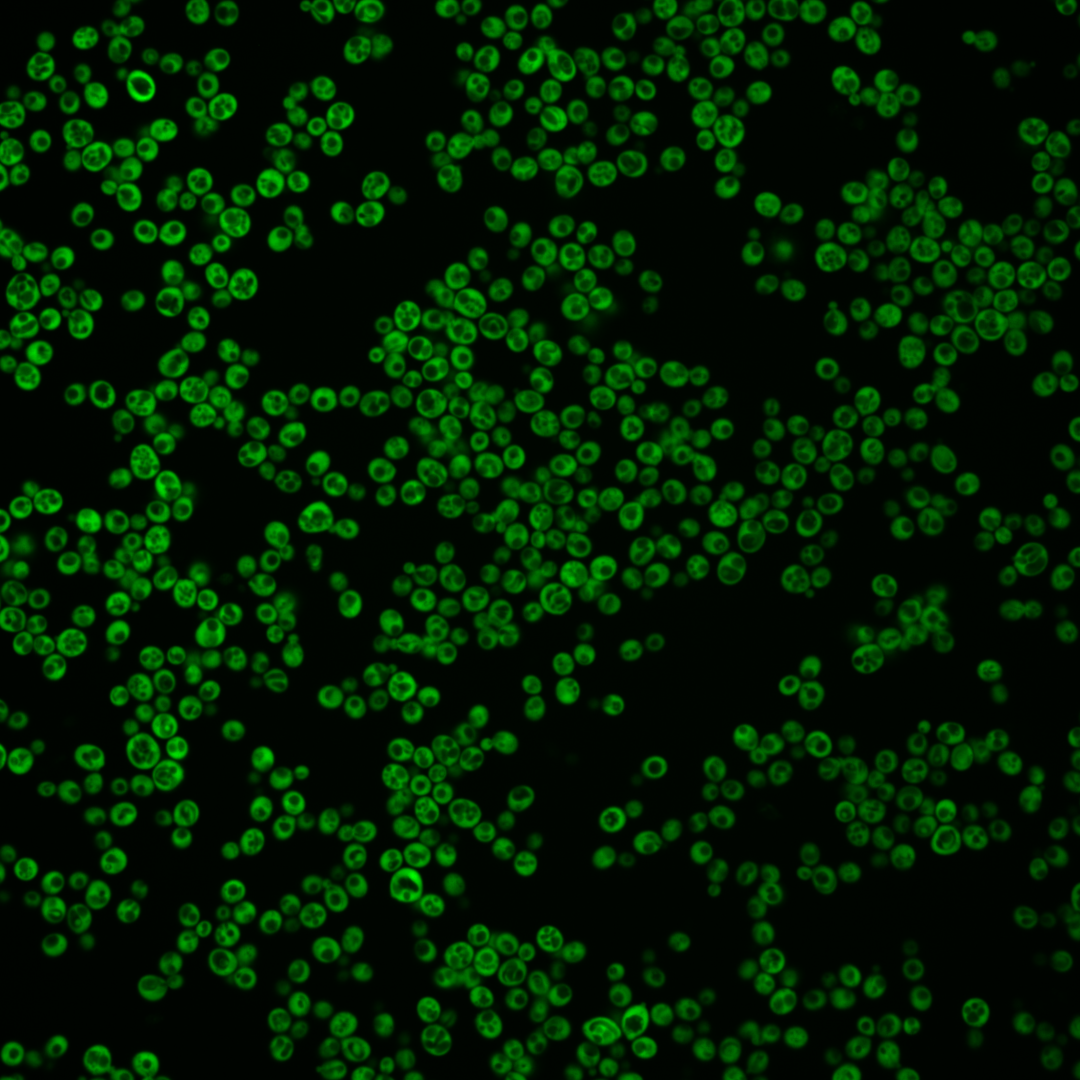
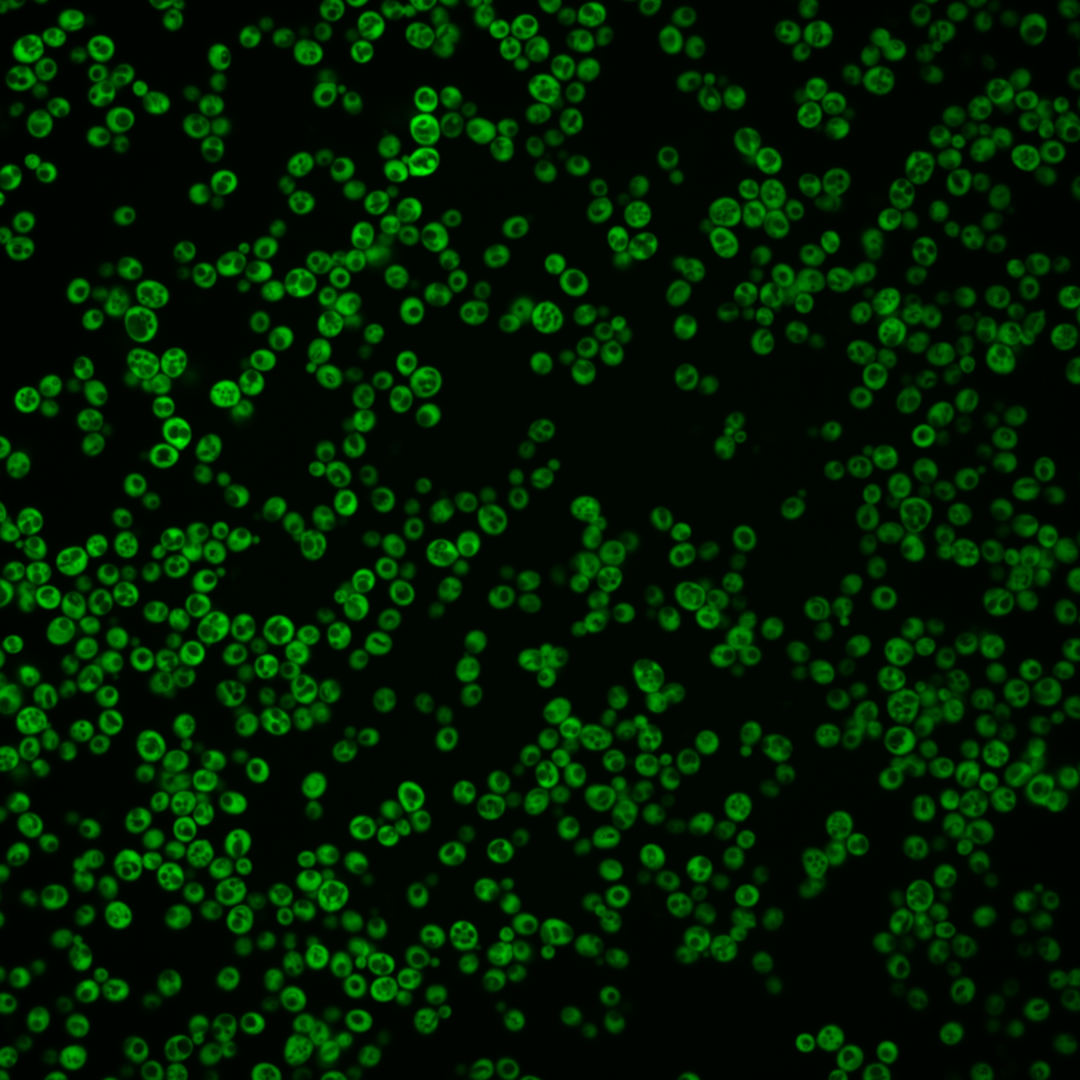
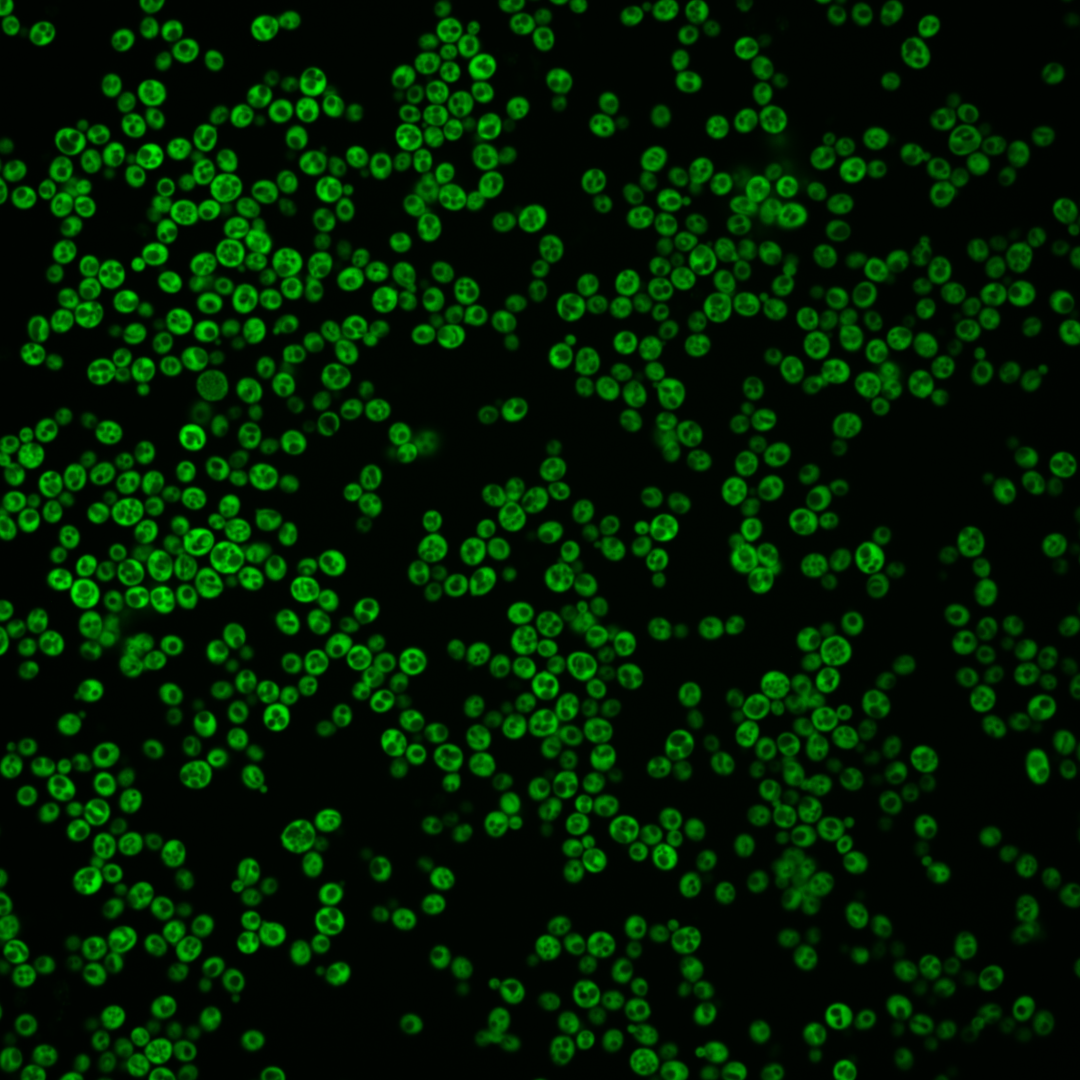
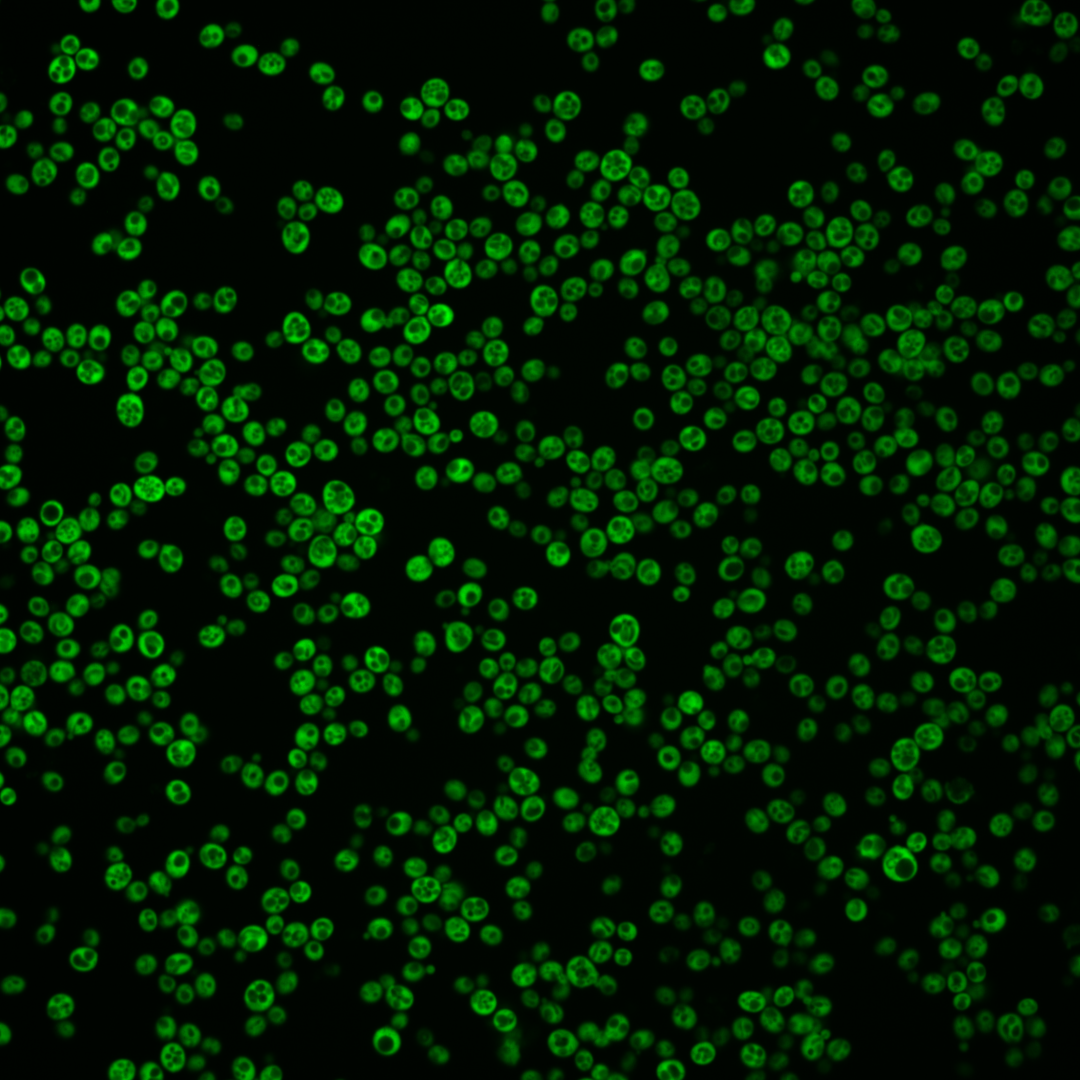

| Standard name | |
|---|---|
| Human Ortholog | |
| Description | Cytosolic leucyl tRNA synthetase; ligates leucine to the appropriate tRNA; human homolog LARS can complement yeast temperature-sensitive mutant at restrictive temperature |
Micrographs




















































































Sub-cellular Localization
Yeast GFP Assignment
Protein Abundance
Localization Change
External localization resources
| ensLOC | DeepLoc | |||||||||||||||||||||||
|---|---|---|---|---|---|---|---|---|---|---|---|---|---|---|---|---|---|---|---|---|---|---|---|---|
| Localization | WT1 | WT2 | WT3 | RAP60 | RAP140 | RAP220 | RAP300 | RAP380 | RAP460 | RAP540 | RAP620 | RAP700 | HU80 | HU120 | HU160 | rpd3Δ_1 | rpd3Δ_2 | rpd3Δ_3 | WT1 | WT2 | WT3 | AF100 | AF140 | AF180 |
| Cortical Patches | 0 | 0 | 0 | 0 | 0 | 4 | 8 | 12 | 14 | 8 | 14 | 27 | 0 | 0 | 0 | 0 | 0 | 0 | 0 | 0 | 0 | 0 | 0 | 0 |
| Bud | 0 | 0 | 1 | 0 | 0 | 0 | 0 | 3 | 2 | 3 | 1 | 6 | 0 | 0 | 1 | 0 | 0 | 0 | 1 | 0 | 0 | 0 | 2 | 2 |
| Bud Neck | 0 | 0 | 0 | 0 | 0 | 0 | 0 | 0 | 0 | 0 | 0 | 0 | 0 | 0 | 0 | 0 | 0 | 0 | 0 | 0 | 0 | 0 | 0 | 0 |
| Bud Site | 0 | 0 | 0 | 0 | 0 | 0 | 0 | 0 | 0 | 0 | 0 | 0 | 0 | 0 | 0 | 0 | 0 | 0 | – | – | – | – | – | – |
| Cell Periphery | 0 | 1 | 13 | 3 | 14 | 17 | 29 | 21 | 32 | 26 | 28 | 53 | 0 | 1 | 5 | 4 | 2 | 1 | 0 | 0 | 1 | 0 | 0 | 0 |
| Cytoplasm | 149 | 98 | 349 | 263 | 348 | 365 | 439 | 389 | 338 | 270 | 245 | 339 | 123 | 221 | 247 | 215 | 176 | 178 | 143 | 98 | 345 | 73 | 184 | 157 |
| Endoplasmic Reticulum | 1 | 2 | 5 | 1 | 9 | 23 | 47 | 62 | 60 | 41 | 58 | 64 | 1 | 2 | 3 | 9 | 11 | 6 | 0 | 0 | 8 | 0 | 4 | 7 |
| Endosome | 0 | 0 | 0 | 0 | 0 | 0 | 0 | 0 | 0 | 0 | 0 | 0 | 0 | 0 | 0 | 0 | 1 | 0 | 0 | 0 | 0 | 0 | 0 | 0 |
| Golgi | 0 | 0 | 0 | 0 | 0 | 1 | 0 | 4 | 0 | 2 | 4 | 3 | 0 | 0 | 0 | 2 | 0 | 0 | 0 | 0 | 0 | 0 | 0 | 0 |
| Mitochondria | 0 | 0 | 0 | 0 | 0 | 1 | 0 | 2 | 14 | 11 | 14 | 27 | 0 | 0 | 0 | 0 | 0 | 0 | 0 | 0 | 0 | 0 | 0 | 0 |
| Nucleus | 0 | 0 | 0 | 0 | 0 | 0 | 0 | 0 | 0 | 0 | 0 | 0 | 0 | 0 | 0 | 0 | 0 | 0 | 0 | 0 | 2 | 0 | 0 | 0 |
| Nuclear Periphery | 0 | 0 | 0 | 0 | 0 | 0 | 0 | 0 | 0 | 0 | 0 | 1 | 0 | 0 | 0 | 0 | 0 | 0 | 0 | 0 | 0 | 0 | 0 | 0 |
| Nucleolus | 0 | 0 | 0 | 0 | 0 | 0 | 0 | 1 | 0 | 0 | 0 | 0 | 0 | 0 | 0 | 0 | 0 | 0 | 0 | 0 | 0 | 0 | 0 | 0 |
| Peroxisomes | 0 | 0 | 0 | 0 | 0 | 0 | 0 | 0 | 0 | 0 | 0 | 0 | 0 | 0 | 0 | 0 | 0 | 0 | 0 | 0 | 0 | 0 | 0 | 0 |
| SpindlePole | 0 | 0 | 0 | 0 | 0 | 0 | 0 | 0 | 0 | 0 | 0 | 0 | 0 | 0 | 0 | 0 | 0 | 0 | 0 | 0 | 0 | 0 | 0 | 0 |
| Vac/Vac Membrane | 0 | 0 | 2 | 0 | 0 | 0 | 0 | 1 | 2 | 1 | 3 | 5 | 0 | 1 | 0 | 3 | 0 | 2 | 0 | 0 | 4 | 0 | 0 | 0 |
| Unique Cell Count | 150 | 100 | 359 | 264 | 357 | 393 | 501 | 475 | 431 | 333 | 326 | 453 | 124 | 223 | 251 | 221 | 178 | 180 | 148 | 101 | 367 | 80 | 199 | 173 |
| Labelled Cell Count | 150 | 101 | 370 | 267 | 371 | 411 | 523 | 495 | 462 | 362 | 367 | 525 | 124 | 225 | 256 | 233 | 190 | 187 | 148 | 101 | 367 | 80 | 199 | 173 |
Yeast GFP Assignment
Protein Abundance
| Screen | WT1 | WT2 | WT3 | RAP60 | RAP140 | RAP220 | RAP300 | RAP380 | RAP460 | RAP540 | RAP620 | RAP700 | HU80 | HU120 | HU160 | rpd3Δ_1 | rpd3Δ_2 | rpd3Δ_3 | AF100 | AF140 | AF180 |
|---|---|---|---|---|---|---|---|---|---|---|---|---|---|---|---|---|---|---|---|---|---|
| Mean Cell GFP Intensity (1e-4) | 109.1 | 97.1 | 64.0 | 63.7 | 56.5 | 45.3 | 41.0 | 37.2 | 32.8 | 31.0 | 29.3 | 28.4 | 97.3 | 92.5 | 81.6 | 123.7 | 135.3 | 136.4 | 99.3 | 108.8 | 112.1 |
| Std Deviation (1e-4) | 28.8 | 21.4 | 14.7 | 14.1 | 10.9 | 9.9 | 9.4 | 8.3 | 8.5 | 8.1 | 7.3 | 6.8 | 25.3 | 18.1 | 15.0 | 40.3 | 43.7 | 46.0 | 33.2 | 35.5 | 35.2 |
| Intensity Change (Log2) | – | – | – | -0.01 | -0.18 | -0.5 | -0.64 | -0.78 | -0.97 | -1.04 | -1.13 | -1.17 | 0.6 | 0.53 | 0.35 | 0.95 | 1.08 | 1.09 | 0.63 | 0.77 | 0.81 |
Localization Change
| Localization | RAP60 | RAP140 | RAP220 | RAP300 | RAP380 | RAP460 | RAP540 | RAP620 | RAP700 | HU80 | HU120 | HU160 | rpd3Δ_1 | rpd3Δ_2 | rpd3Δ_3 |
|---|---|---|---|---|---|---|---|---|---|---|---|---|---|---|---|
| Cortical Patches | 0 | 0 | 0 | 0 | 3.0 | 3.4 | 0 | 4.0 | 4.7 | 0 | 0 | 0 | 0 | 0 | 0 |
| Bud | 0 | 0 | 0 | 0 | 0 | 0 | 0 | 0 | 0 | 0 | 0 | 0 | 0 | 0 | 0 |
| Bud Neck | 0 | 0 | 0 | 0 | 0 | 0 | 0 | 0 | 0 | 0 | 0 | 0 | 0 | 0 | 0 |
| Bud Site | 0 | 0 | 0 | 0 | 0 | 0 | 0 | 0 | 0 | 0 | 0 | 0 | 0 | 0 | 0 |
| Cell Periphery | -1.9 | 0.2 | 0.5 | 1.5 | 0.6 | 2.3 | 2.4 | 2.7 | 4.2 | 0 | -2.4 | -1.2 | -1.3 | 0 | 0 |
| Cytoplasm | 2.3 | 0.2 | -2.7 | -5.0 | -6.9 | -7.8 | -6.9 | -8.5 | -8.8 | 1.3 | 1.6 | 1.0 | 0.1 | 1.2 | 1.2 |
| Endoplasmic Reticulum | 0 | 1.1 | 3.2 | 4.8 | 6.1 | 6.4 | 5.8 | 7.4 | 6.5 | 0 | 0 | 0 | 2.0 | 3.1 | 0 |
| Endosome | 0 | 0 | 0 | 0 | 0 | 0 | 0 | 0 | 0 | 0 | 0 | 0 | 0 | 0 | 0 |
| Golgi | 0 | 0 | 0 | 0 | 0 | 0 | 0 | 0 | 0 | 0 | 0 | 0 | 0 | 0 | 0 |
| Mitochondria | 0 | 0 | 0 | 0 | 0 | 3.4 | 3.5 | 4.0 | 4.7 | 0 | 0 | 0 | 0 | 0 | 0 |
| Nucleus | 0 | 0 | 0 | 0 | 0 | 0 | 0 | 0 | 0 | 0 | 0 | 0 | 0 | 0 | 0 |
| Nuclear Periphery | 0 | 0 | 0 | 0 | 0 | 0 | 0 | 0 | 0 | 0 | 0 | 0 | 0 | 0 | 0 |
| Nucleolus | 0 | 0 | 0 | 0 | 0 | 0 | 0 | 0 | 0 | 0 | 0 | 0 | 0 | 0 | 0 |
| Peroxisomes | 0 | 0 | 0 | 0 | 0 | 0 | 0 | 0 | 0 | 0 | 0 | 0 | 0 | 0 | 0 |
| SpindlePole | 0 | 0 | 0 | 0 | 0 | 0 | 0 | 0 | 0 | 0 | 0 | 0 | 0 | 0 | 0 |
| Vacuole | 0 | 0 | 0 | 0 | 0 | 0 | 0 | 0 | 0 | 0 | 0 | 0 | 0 | 0 | 0 |
External localization resources
Images






























Protein Concentration and Protein Localization Data
| R1 | R2 | R3 | ||||||||||||||||
|---|---|---|---|---|---|---|---|---|---|---|---|---|---|---|---|---|---|---|
| G1 Pre-START | G1 Post-START | S/G2 | Metaphase | Anaphase | Telophase | G1 Pre-START | G1 Post-START | S/G2 | Metaphase | Anaphase | Telophase | G1 Pre-START | G1 Post-START | S/G2 | Metaphase | Anaphase | Telophase | |
| Concentration | 85.0979 | 137.8913 | 116.7705 | 123.9341 | 109.8733 | 115.5246 | 92.6923 | 138.3405 | 120.4337 | 98.8657 | 115.8812 | 114.3651 | 100.4902 | 143.9924 | 123.2225 | 111.1639 | 116.5823 | 119.4024 |
| Actin | 0.0461 | 0.0007 | 0.0037 | 0.0002 | 0.0005 | 0.0334 | 0.0094 | 0.0004 | 0.0054 | 0.006 | 0.0007 | 0.0067 | 0.0024 | 0.0002 | 0.0087 | 0.0011 | 0.001 | 0.0009 |
| Bud | 0.0035 | 0.0011 | 0.0028 | 0.0018 | 0.0011 | 0.0015 | 0.0021 | 0.0004 | 0.0035 | 0.0031 | 0.0013 | 0.0008 | 0.002 | 0.0002 | 0.0012 | 0.0016 | 0.0011 | 0.0046 |
| Bud Neck | 0.0018 | 0.0011 | 0.0025 | 0.0008 | 0.0027 | 0.0034 | 0.0004 | 0.0002 | 0.0005 | 0.0012 | 0.0007 | 0.0011 | 0.0008 | 0.0004 | 0.0014 | 0.0008 | 0.0012 | 0.0033 |
| Bud Periphery | 0.0032 | 0.0008 | 0.0039 | 0.0005 | 0.0007 | 0.0018 | 0.0027 | 0.0002 | 0.0037 | 0.0066 | 0.0007 | 0.0009 | 0.0019 | 0.0001 | 0.0008 | 0.0015 | 0.001 | 0.0036 |
| Bud Site | 0.0048 | 0.0011 | 0.0025 | 0.0002 | 0.0002 | 0.0008 | 0.0025 | 0.0002 | 0.003 | 0.0065 | 0.0005 | 0.0004 | 0.0021 | 0.0002 | 0.0019 | 0.0005 | 0.001 | 0.0004 |
| Cell Periphery | 0.0287 | 0.03 | 0.0443 | 0.0037 | 0.0198 | 0.0043 | 0.0091 | 0.0032 | 0.0099 | 0.0319 | 0.0023 | 0.0003 | 0.0152 | 0.0064 | 0.0122 | 0.0367 | 0.0069 | 0.0075 |
| Cytoplasm | 0.4307 | 0.7996 | 0.6322 | 0.6085 | 0.5872 | 0.5834 | 0.7813 | 0.9769 | 0.8717 | 0.7568 | 0.8805 | 0.8976 | 0.7709 | 0.9582 | 0.8621 | 0.7141 | 0.8058 | 0.765 |
| Cytoplasmic Foci | 0.0326 | 0.0005 | 0.01 | 0.0008 | 0.048 | 0.0041 | 0.0127 | 0.0008 | 0.0097 | 0.003 | 0.0101 | 0.0111 | 0.0099 | 0.0006 | 0.0064 | 0.0026 | 0.0047 | 0.0229 |
| Eisosomes | 0.0008 | 0.0001 | 0.0004 | 0 | 0.0003 | 0.0002 | 0.0002 | 0 | 0.0001 | 0.0002 | 0.0003 | 0 | 0.0004 | 0 | 0.0002 | 0.0003 | 0.0004 | 0.0001 |
| Endoplasmic Reticulum | 0.0533 | 0.0187 | 0.02 | 0.0021 | 0.0109 | 0.0763 | 0.0375 | 0.0026 | 0.0107 | 0.0102 | 0.0027 | 0.0084 | 0.039 | 0.0114 | 0.0116 | 0.0088 | 0.0122 | 0.0303 |
| Endosome | 0.0149 | 0.0012 | 0.0062 | 0.0041 | 0.007 | 0.0189 | 0.0146 | 0.0009 | 0.0046 | 0.0224 | 0.0041 | 0.0379 | 0.0103 | 0.0006 | 0.0064 | 0.0174 | 0.0098 | 0.0103 |
| Golgi | 0.0071 | 0.0002 | 0.0038 | 0.0002 | 0.0004 | 0.005 | 0.0038 | 0.0002 | 0.0011 | 0.0029 | 0.0006 | 0.0074 | 0.0016 | 0.0001 | 0.0013 | 0.0012 | 0.0018 | 0.0026 |
| Lipid Particles | 0.0169 | 0.0007 | 0.0123 | 0.0003 | 0.0105 | 0.0064 | 0.0035 | 0.0004 | 0.0024 | 0.0008 | 0.0059 | 0.0008 | 0.0028 | 0.0008 | 0.0013 | 0.0013 | 0.0015 | 0.0032 |
| Mitochondria | 0.0292 | 0.0075 | 0.0131 | 0.0005 | 0.0222 | 0.0104 | 0.0061 | 0.0001 | 0.0039 | 0.0224 | 0.0096 | 0.0029 | 0.0126 | 0 | 0.0106 | 0.0142 | 0.0302 | 0.0337 |
| None | 0.0171 | 0.0002 | 0.0043 | 0.0002 | 0.0045 | 0.0017 | 0.0085 | 0.0001 | 0.0035 | 0.0003 | 0.015 | 0.0012 | 0.0049 | 0.0001 | 0.0028 | 0.0022 | 0.0017 | 0.0056 |
| Nuclear Periphery | 0.0515 | 0.0072 | 0.0203 | 0.0163 | 0.014 | 0.0162 | 0.0225 | 0.0012 | 0.0023 | 0.008 | 0.0051 | 0.0033 | 0.02 | 0.0013 | 0.0072 | 0.0167 | 0.0047 | 0.0075 |
| Nucleolus | 0.0203 | 0.0002 | 0.0043 | 0.0005 | 0.0052 | 0.0104 | 0.0023 | 0.0001 | 0.0008 | 0.0003 | 0.0112 | 0.0001 | 0.003 | 0 | 0.0037 | 0.0009 | 0.0032 | 0.0056 |
| Nucleus | 0.0161 | 0.0033 | 0.0144 | 0.0058 | 0.0071 | 0.0351 | 0.0066 | 0.001 | 0.0023 | 0.0026 | 0.0066 | 0.0014 | 0.0099 | 0.0009 | 0.0042 | 0.0073 | 0.0048 | 0.006 |
| Peroxisomes | 0.0123 | 0 | 0.0039 | 0.0001 | 0.0029 | 0.0044 | 0.0004 | 0 | 0.0003 | 0.0002 | 0.0003 | 0.0014 | 0.0003 | 0 | 0.0003 | 0.0001 | 0.0002 | 0.0006 |
| Punctate Nuclear | 0.0144 | 0 | 0.0011 | 0 | 0.0004 | 0.0018 | 0.0046 | 0 | 0.0013 | 0.0001 | 0.0006 | 0.0017 | 0.0014 | 0 | 0.0003 | 0.0002 | 0.0002 | 0.0002 |
| Vacuole | 0.1548 | 0.1141 | 0.1646 | 0.2366 | 0.2139 | 0.1053 | 0.0607 | 0.0103 | 0.0498 | 0.0882 | 0.0234 | 0.0102 | 0.0741 | 0.0176 | 0.0494 | 0.1401 | 0.0893 | 0.0684 |
| Vacuole Periphery | 0.0398 | 0.0116 | 0.0293 | 0.1171 | 0.0405 | 0.0752 | 0.0086 | 0.0008 | 0.0095 | 0.0264 | 0.0178 | 0.0044 | 0.0144 | 0.0008 | 0.0058 | 0.0306 | 0.0173 | 0.0178 |
Sequencing Data
| R1 | R2 | |||||||||
|---|---|---|---|---|---|---|---|---|---|---|
| G1 Post-START | S/G2 | Metaphase | Anaphase | Telophase | G1 Post-START | S/G2 | Metaphase | Anaphase | Telophase | |
| Gene Expression | 293.6344 | 282.3814 | 298.9903 | 321.2449 | 299.4101 | 263.8214 | 266.7758 | 252.7566 | 244.4966 | 284.315 |
| Translational Efficiency | 1.1557 | 1.231 | 1.1525 | 1.138 | 1.1582 | 1.0841 | 1.0717 | 0.9707 | 0.9789 | 0.9924 |
Hit Data
| Dataset | Hit |
|---|---|
| Protein Concentration | ✘ |
| Protein Localization | ✘ |
| Gene Expression | ✘ |
| Translational Efficiency | ✘ |
Endocytosis
| Temp | Actin Patch (Sac6-tdTomato) | Cortical Patch (Sla1-GFP) | Late Endosome (Snf7-GFP) | Vacuole (Vph1-GFP) |
|---|---|---|---|---|
| 37℃ | ||||
| RT |
Cell Cycle Omics
CYCLoPs (Cdc60-GFP)
| Gene / Allele | Actin Patch (Sac6-tdTomato) | Cortical Patch (Sla1-GFP) | Late Endosome (Snf7-GFP) | Vacuole (Sac6-tdTomato) |
|---|
| Gene | Images |
|---|
| Gene | Images |
|---|
Images are not yet available
Images are not yet available